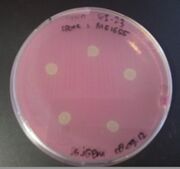
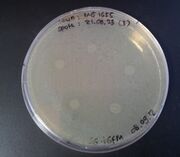
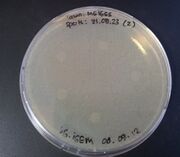
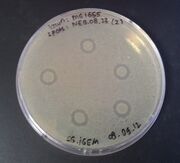
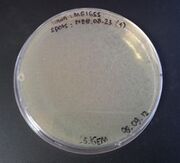
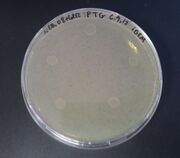
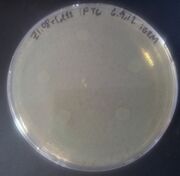
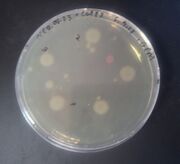
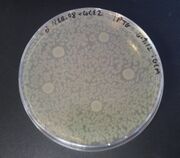
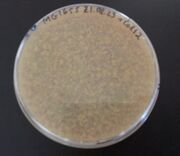
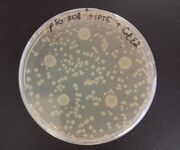
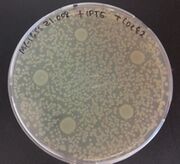
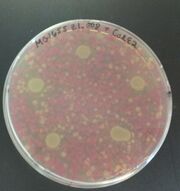
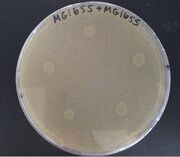
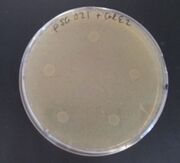
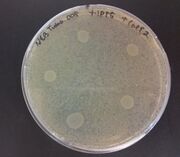
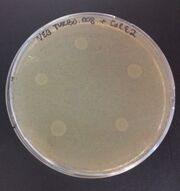

Uploads by Julianne M. Rieders
From OpenWetWare
Jump to navigationJump to search
This special page shows all uploaded files.
| Date | Name | Thumbnail | Size | Description |
|---|---|---|---|---|
| 13:27, 22 September 2012 | SGgel190912.jpg (file) |  |
56 KB | |
| 13:15, 22 September 2012 | SGgel1809122.jpg (file) |  |
62 KB | |
| 13:15, 22 September 2012 | SGgel180912.jpg (file) |  |
61 KB | |
| 09:04, 17 September 2012 | SGZ123WT080912.jpg (file) | |
216 KB | |
| 09:03, 17 September 2012 | SGZ123C2080912.jpg (file) |  |
659 KB | |
| 09:03, 17 September 2012 | SGWTZ108233080912.jpg (file) | |
247 KB | |
| 09:03, 17 September 2012 | SGWTZ108232080912.jpg (file) | |
232 KB | |
| 09:00, 17 September 2012 | SGWTZ108231080912.jpg (file) |  |
276 KB | |
| 08:58, 17 September 2012 | SGWTNB08233080912.jpg (file) |  |
181 KB | |
| 08:51, 17 September 2012 | SGWTNB08232080912.jpg (file) | |
181 KB | |
| 08:51, 17 September 2012 | SGWTNB08231080912.jpg (file) | |
201 KB | |
| 08:50, 17 September 2012 | SGWTC2080912.jpg (file) |  |
211 KB | |
| 15:49, 7 September 2012 | SGNEB08+C2060912.jpg (file) | |
531 KB | |
| 15:43, 7 September 2012 | SGZ108+C2060912.jpg (file) | |
200 KB | |
| 15:42, 7 September 2012 | SGNEB0823C2060912.jpg (file) | |
207 KB | |
| 15:41, 7 September 2012 | SGWTC2060912.jpg (file) |  |
215 KB | |
| 15:16, 7 September 2012 | SGdZ108+C2060912.jpg (file) |  |
608 KB | |
| 15:16, 7 September 2012 | SGZ108C2060912.jpg (file) |  |
643 KB | |
| 15:09, 7 September 2012 | SGWTWT023060912.jpg (file) |  |
592 KB | |
| 15:08, 7 September 2012 | SGWT023C2060912.jpg (file) |  |
637 KB | |
| 15:08, 7 September 2012 | SGdNEB08C2060912.jpg (file) |  |
714 KB | |
| 15:08, 7 September 2012 | SGdNEB08+C2060912.jpg (file) | |
561 KB | |
| 14:59, 7 September 2012 | SGZ10823+C2060912.jpg (file) |  |
604 KB | |
| 14:59, 7 September 2012 | SGZ10823C2060912.jpg (file) |  |
547 KB | |
| 14:42, 7 September 2012 | SGNEB0823+C2060912.jpg (file) |  |
207 KB | |
| 14:42, 7 September 2012 | SGdZ10823+C2060912.jpg (file) |  |
802 KB | |
| 14:41, 7 September 2012 | SGdNEB0823+C2060912.jpg (file) |  |
691 KB | |
| 17:59, 6 September 2012 | SGgel0609122.jpg (file) |  |
141 KB | |
| 17:58, 6 September 2012 | SGgel0609121.jpg (file) |  |
76 KB | |
| 14:35, 5 September 2012 | SGgel030912.jpg (file) |  |
102 KB | |
| 16:09, 31 August 2012 | SGassZ123C2300812F.jpg (file) |  |
559 KB | |
| 15:14, 31 August 2012 | SGassZ123C2300812.jpg (file) |  |
780 KB | |
| 15:13, 31 August 2012 | SGassZ1823IPTGCE2300812.jpg (file) | |
528 KB | |
| 14:06, 31 August 2012 | SGassZ1823IPTGC2300812F.jpg (file) |  |
109 KB | |
| 12:38, 31 August 2012 | SGassZ1823C2300812.jpg (file) |  |
336 KB | |
| 10:41, 31 August 2012 | SGassZ1823IPTGC2300812.jpg (file) |  |
677 KB | |
| 10:40, 31 August 2012 | SGassNB08CE2300812.jpg (file) |  |
734 KB | |
| 10:40, 31 August 2012 | SGassNB8C2300812.jpg (file) | |
658 KB | |
| 14:59, 30 August 2012 | SGassZ1.08.23IPTGCE2290812.jpg (file) | |
243 KB | |
| 14:59, 30 August 2012 | SGassZ1.08.23CE2290812.jpg (file) | |
361 KB | |
| 14:59, 30 August 2012 | SGassWTWT290812.jpg (file) | |
237 KB | |
| 14:58, 30 August 2012 | SGassWTCE2290812.jpg (file) |  |
227 KB | |
| 14:58, 30 August 2012 | SGasspSG21IPTGCE2290812.jpg (file) |  |
160 KB | |
| 14:58, 30 August 2012 | SGasspSG21CE2290812.jpg (file) | |
190 KB | |
| 14:58, 30 August 2012 | SGasspSG08IPTGCE2290812.jpg (file) | |
237 KB | |
| 14:57, 30 August 2012 | SGasspSG08CE2290812.jpg (file) | |
200 KB | |
| 15:14, 29 August 2012 | SGgel2908121.jpg (file) |  |
47 KB | |
| 17:04, 28 August 2012 | SGgel280812.jpg (file) |  |
94 KB | |
| 09:54, 27 August 2012 | SGgel2308121.jpg (file) |  |
64 KB | |
| 14:07, 22 August 2012 | PSG21C2220812.jpg (file) |  |
565 KB |